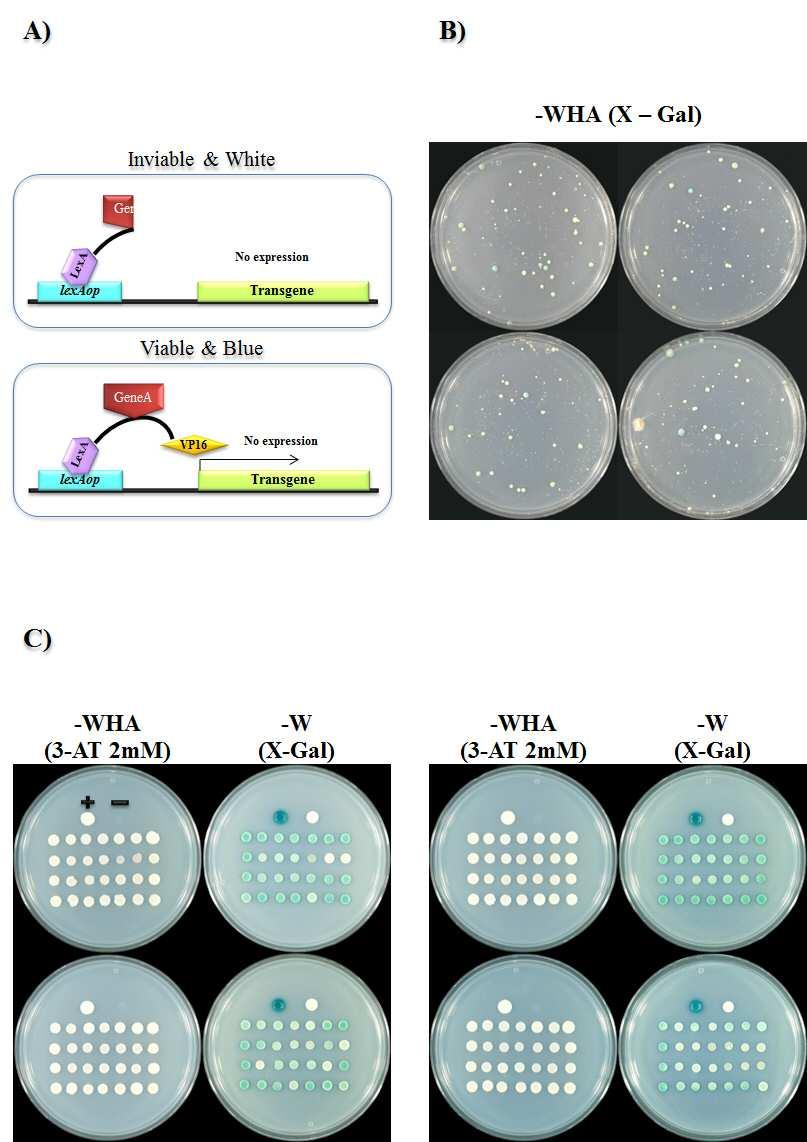

출원번호 : 10-2015-0107272 (2015년07월29일)
등록번호 : 10-1768770 (2017년08월09일)
특허권자 : 배재대학교 산학협력단
요약 :
본 발명은 단백질 발현을 위한 유전자 합성과정에서 의도하지 않는 해독틀 변형 염기오류, 즉 염기의 결손 및 삽입과 종결코돈의 돌연변이가 포함되지 않는 클론을 선택적으로 선별하기 위한 것이다.
이를 위하여 효모를 이용하여 본 발명에서 제조된 E. coli-Yeast shuttle vector에 존재하는 대장균의 LexA 단백질 중 DNA 결합부위 (LexA DBD, LexA DNA Binding Domain)와 전사활성화 단백질인 VP16 사이에 합성 유전자를 일상적인 제한효소와 리가아제의 사용없이 효모의 in vivo cloning을 통하여 삽입하고, 해독틀 변이 및 종결 돌연변이가 없는 유전자가 존재할 경우에만 VP16이 생성되게 함으로써, 숙주 효모에 존재하며 LexA DBD와 결합하는 operator를 포함하고 있는 HIS3, ADE2의 리포터 유전자들을 발현시켜 히스티딘 및 아데닌 영양요구성 숙주 효모가 최소배지에서 생장할 수 있게 함으로써 합성 유전자의 클로닝과 동시에 해독틀 변이 및 종결코돈 돌연변이가 없는 유전자를 선택적으로 선별하는 방법이다.